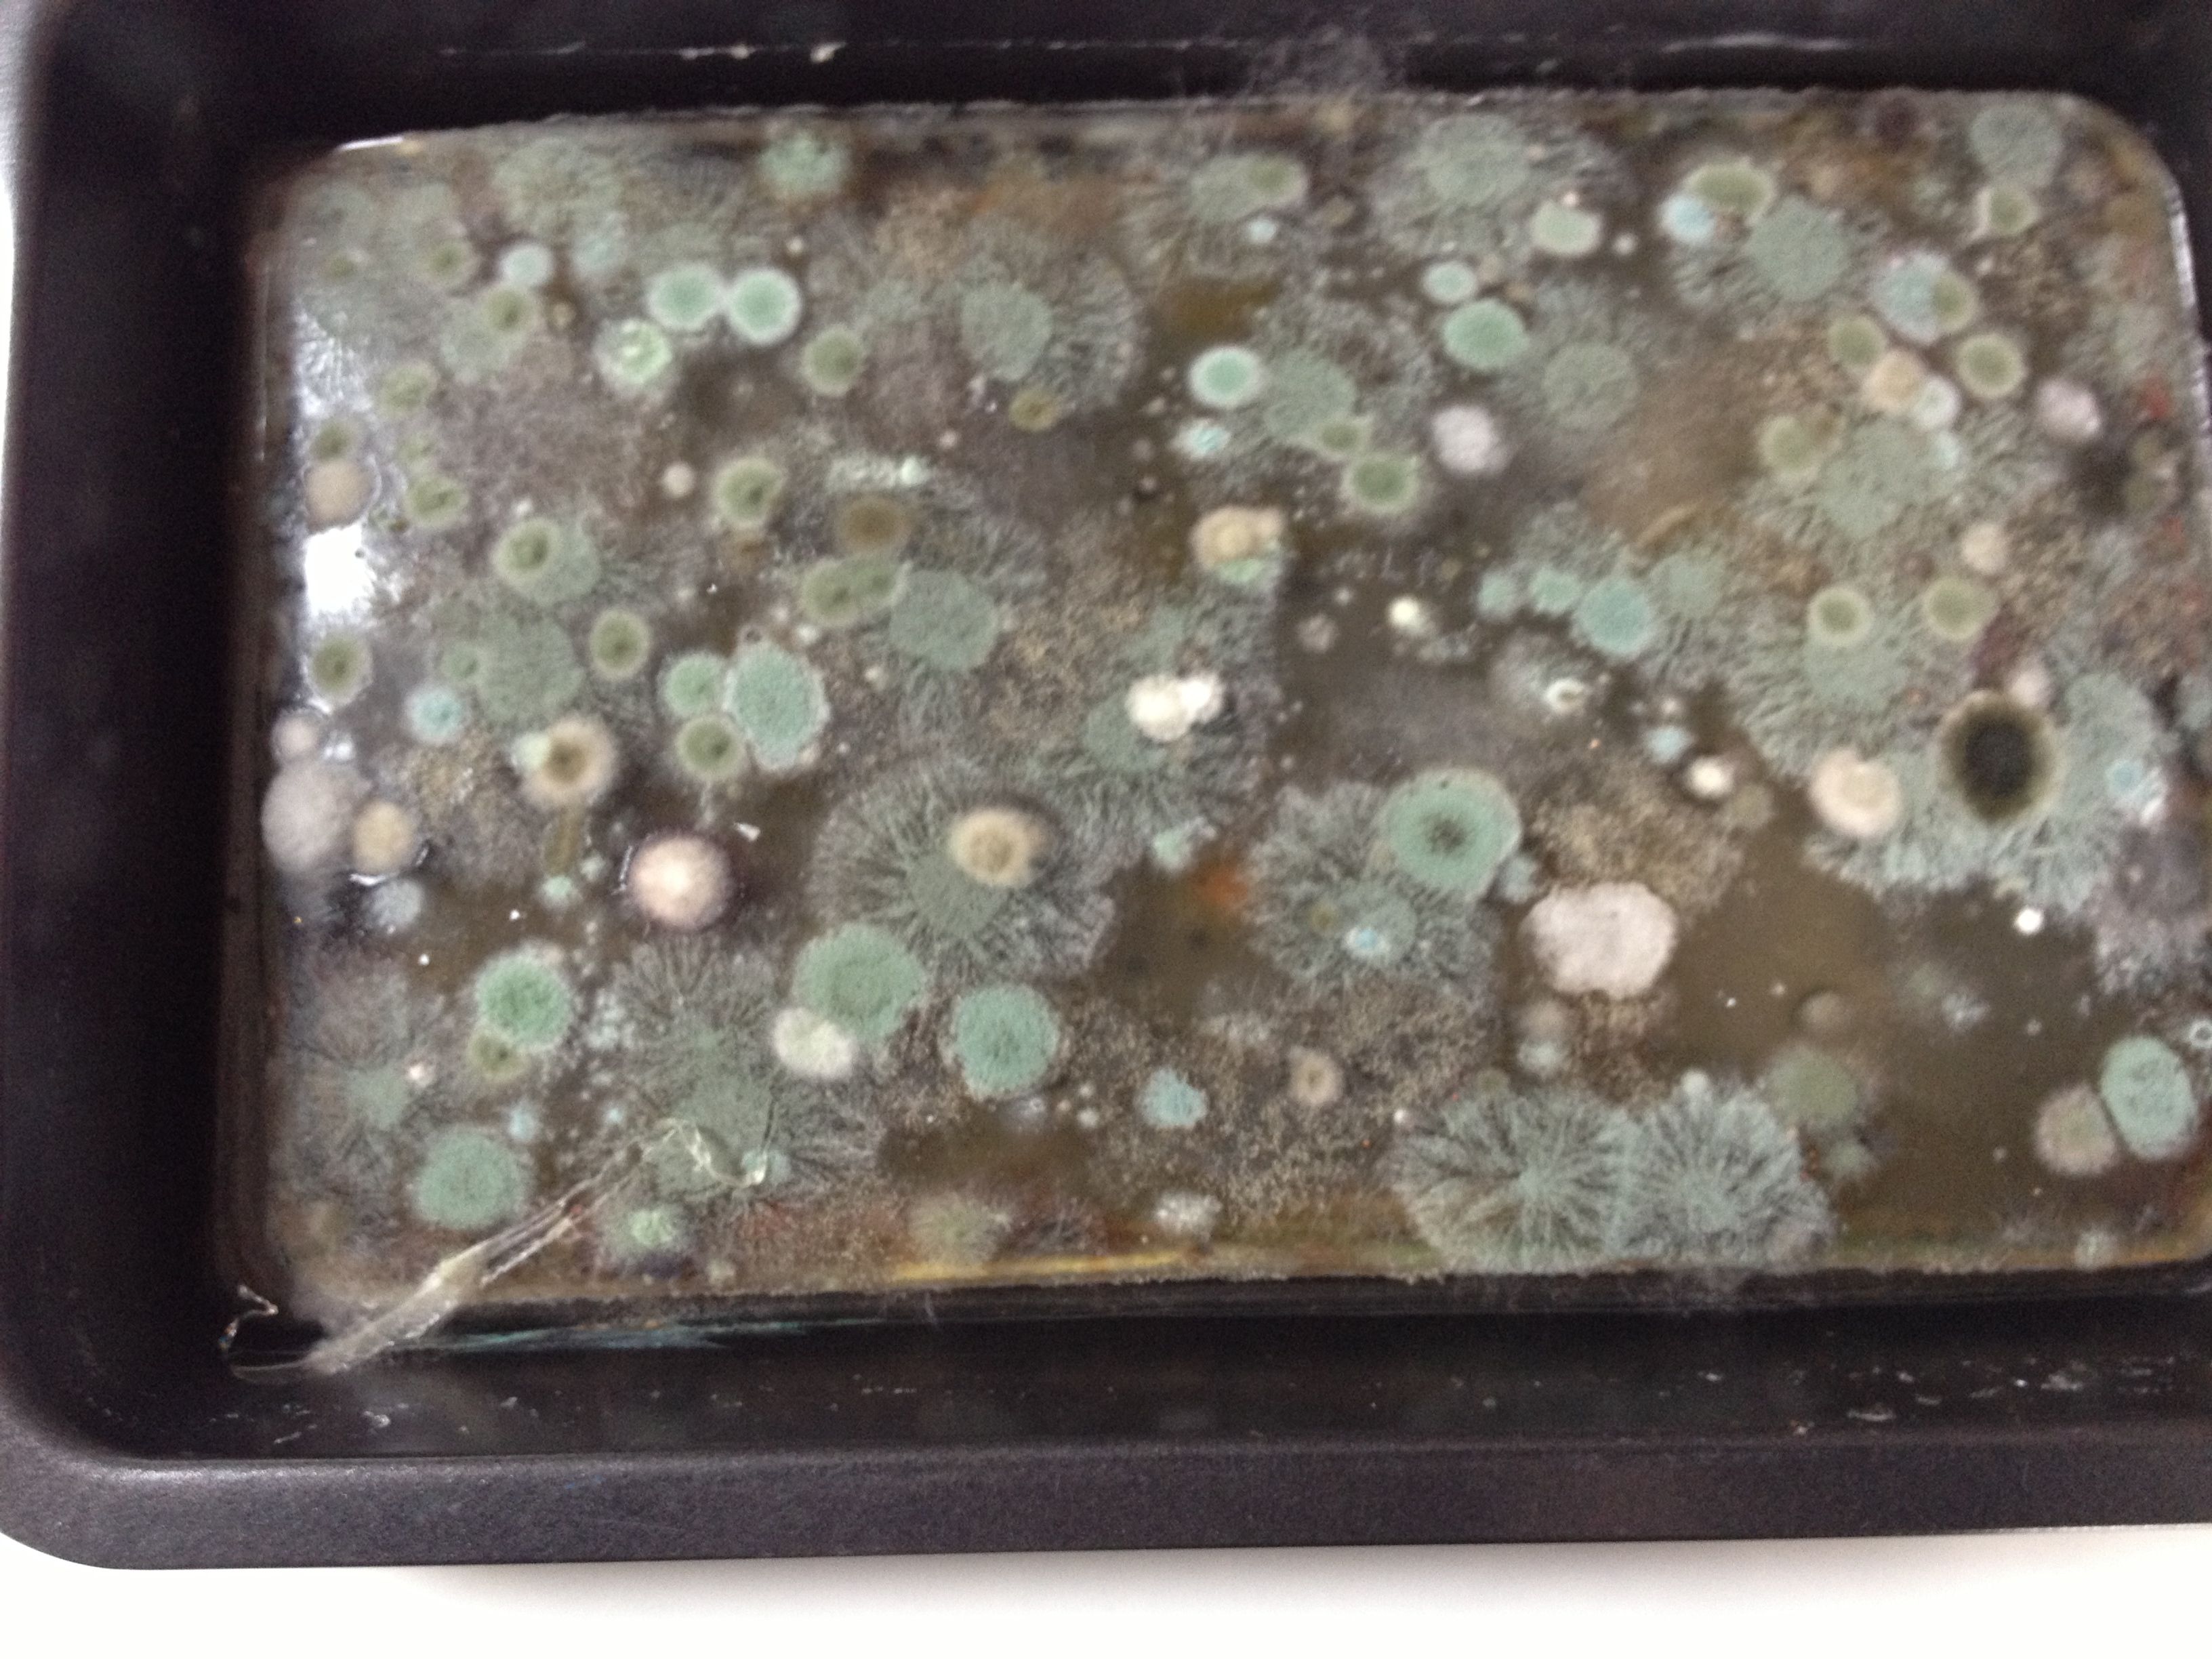

Spent a day in the studio, or the better part thereof. Mostly I carved tiny pink worms from a Speedball plate. Made mistakes but learned how to do it better next time. These Islamic patterns are endlessly fascinating but devilishly tricky to reproduce. This time I used an inverted drinking glass for the circle.
Playing with stencils, I traced a Swallowtail from a butterfly book, modified it, used clear mylar. I think the stencils are nicer if they’re cut from heavy paper and coated with matte medium like LG suggested, but I can’t quite find my matte medium. The pine needles my daughter gathered were a pleasant surprise, they held onto ink and reproduced the color in surprising ways. I thought they would be more blobby.
Looking at my prints from last year, I need new photographs to work from in order to make new stencils. So the next project is to invite a yogi friend over to practice, and hope she doesn’t mind if I take a few pictures. Volunteers?
This is the plate I spent a few hours carving. Already I need to start another as I can see how it could be better now.
While cutting stencils I made a corrugated cardboard version of the butterfly. It didn’t work so well here, but I’ll try again with more colors.
Warning- not for the faint of heart. This is what happens when your gelatin plate (no glycerin in this one) goes BAD:
Eew! Beautiful too though. Reminds me of a story a roofer told me about a guy in New Orleans who closed up his house and left. Came back to a mold colony that was unbelievable. I think they had to seal off the house in plastic and go in in haz mat suits. Still, it was beautiful in it’s own poisonous way.
I could spend days here… love the new studio!